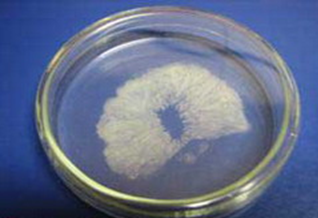

Privoščite si 5% popusta za gobji odmerek dobrega počutja in se pridružite skupnosti GOBA!
Tistim, ki si ne želimo le hitrih rešitev, ampak trajnega ravnovesja. Tistim, ki razumemo, da zdravje ni cilj, ampak način življenja. Tistim, ki ne iščemo le prehranskega dopolnila, ampak spremljevalca na poti k dobremu počutju. Ker včasih najmanjše stvari prinesejo največje spremembe. Ob prvem nakupu vas čaka 5% popusta - kot drobna zahvala za vaše zaupanje.